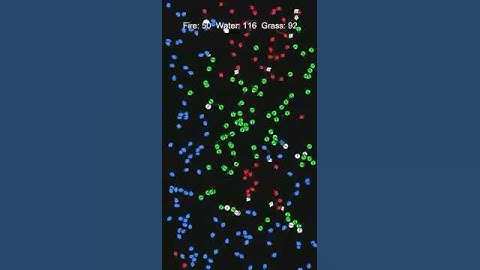
Fire vs Water vs Grass: Map Domination Test #rockpaperscissors #unity #music #yukika

⬇ DOWNLOAD NOW
Jika muncul iklan pop-up, tutup lalu klik tombol kembali
Download lagu Fire vs Water vs Grass: Infinite Loop Battle #rockpaperscissors #unity #simulation ation secara gratis hanya untuk keperluan promosi. Dukung artis favorit kamu dengan membeli musik original di iTunes atau platform resmi lainnya.
Fire vs Water vs Grass: Map Domination Test #rockpaperscissors #unity #music #yukika
Fire vs Water vs Grass: Map Domination Test #rockpaperscissors #unity #music #yukika Fire vs Water vs Grass: Patterns We Didn’t Expect #rockpaperscissors #unity #simulation
Fire vs Water vs Grass: Patterns We Didn’t Expect #rockpaperscissors #unity #simulation Fire vs Water vs Grass: In Search of Balance #rockpaperscissors #unity #simulation #music
Fire vs Water vs Grass: In Search of Balance #rockpaperscissors #unity #simulation #music Fire vs Water vs Grass: One Rule, Endless Drama #rockpaperscissors #unity #simulation #citypop
Fire vs Water vs Grass: One Rule, Endless Drama #rockpaperscissors #unity #simulation #citypop Fire vs Water vs Grass: Counter Cycle Unleashed #rockpaperscissors #unity #simulation
Fire vs Water vs Grass: Counter Cycle Unleashed #rockpaperscissors #unity #simulation Fire vs Water vs Grass: Back-and-Forth Until the Very End #rockpaperscissors #unity #simulation
Fire vs Water vs Grass: Back-and-Forth Until the Very End #rockpaperscissors #unity #simulation Fire vs Water vs Grass: Rock–Paper–Scissors Chaos #rockpaperscissors #unity #simulation
Fire vs Water vs Grass: Rock–Paper–Scissors Chaos #rockpaperscissors #unity #simulation Fire vs Water vs Grass: Lessons from a Tiny World #rockpaperscissors #kpop #unity #simulation
Fire vs Water vs Grass: Lessons from a Tiny World #rockpaperscissors #kpop #unity #simulation